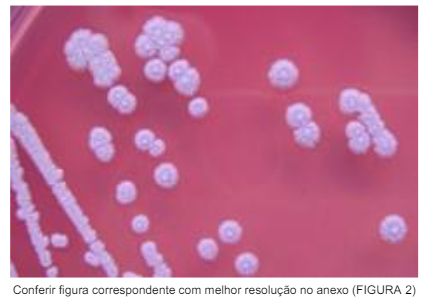
Enunciado 3770493-1

Em 2003, houve um surto de melioidose na cidade de Tejuçuoca, no Ceará, trazendo à Fortaleza americanos da
Vigilância Estratégica, do CDC (Centers for Disease Control and Prevention). Para comparar, lembremos que
existe, dentre muitas outras hipóteses, a de que a peste de Atenas, do século de Péricles, que inclusive vitimou
o estadista, poderia ter sido também de melioidose; tal é a especulação de João Alves Meira, como citada por
Antônio Bernardo de Oliveira em A Evolução da Medicina até o Início do Século XX.

Sobre a vigilância da melioidose, qual assertiva está correta?
Sobre a vigilância da melioidose, qual assertiva está correta?